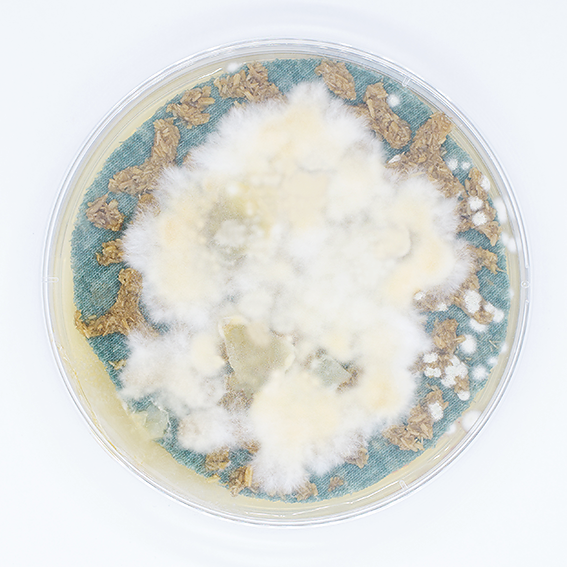

Das Projekt About fungi, hemp and medical technology schlägt eine Brücke zwischen dem Kos mos der Mikroorganismen und der Medizintechnik. Der Pilz Fomes Fomentarius, auch Zunder schwamm genannt, besitzt eine lange Geschichte in der medizinischen Anwendung, so wurde
er aufgrund seiner heilenden Wirkung früher als Wundauflage verwendet. Die Synergie zwi schen diesen Heilkräften des Zunderschwamms und seiner Fähigkeit zur Myzelbildung inspirier te meine Forschungsversuche.
Explorativ entstanden Materialproben aus Myzelverbundstoffen, wie Hanf und Alginat. Als Bin demittel dient das Hydrogel Alginat, das in pastöser Konzentration auch 3D-gedruckt werden kann. Auf ein Textil aufgetragen, bewirkte der mit Myzel durchzogene Verbundstoff eine partiel le Versteifung, die die Stabilisierungswirkung einer Orthese nachbilden kann.
Orthesen bestehen derzeit aus schwer trennbaren Verbundmaterialien. Durch den Einsatz von Myzelverbundwerkstoffen und den Verzicht auf fossile Materialien werden in diesem Projekt nachhaltige Lösungen erarbeitet, die zudem kompostierbar sind.